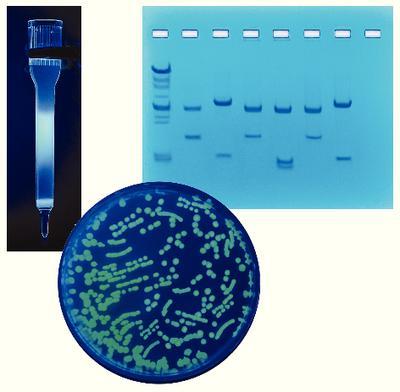

Purif And Size Deter Of Gfp ,Each
$ 143.52
|
|
Details:
PURIF AND SIZE DETER OF GFP
Additional Information
| SKU | 23299596 |
|---|---|
| UOM | EACH |
| UNSPSC | 41105318 |
| Manufacturer Part Number | 255-B |
| Product Dimensions | 12X10X4 Inches |
| Product Weight | 4.5 |
